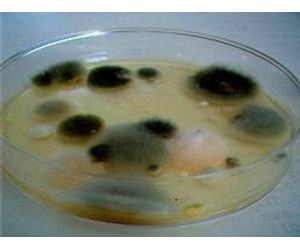

Mold Remediation & Cleanup
Microscopic mold spores are present everywhere: within our walls, in our air, on our food, and anywhere else you can think of! Mold spores are much like plant seeds: they need just the right conditions to grow.Moisture and lack of sunlight both contribute to the growth of mold spores. Mold can be very useful in natural processes such as decomposition and aging cheese.When mold is present indoors, it can cause structural damage and health hazards. For optimum safety, indoor molds must be remediated and properly cleaned up as soon as possible!
How Apple Environmental Can Help
Our formula stops mold dead in its tracks and actively works to prevent any regrowth. When applied directly on affected areas, it effectively kills mold, mildew, and spore growth. Our trained and certified technicians will have your property’s air back to normal in no time!
Apple Environment can effectively treat areas such as:
- All Indoor Surfaces
- Asphalt or Cedar Roofing Shingles
- Cedar Decks
- Treated Decks
- Vinyl Fences and Siding
- Stucco, Brick and Other Types of Facings
- And More!
Mold remediation requires thorough cleanup and decontamination. Our mold remediation professionals can get your home safe from mold and health hazards. Our formula is biodegradable, non-toxic, non-flammable, and will outperform any remediation chemical available.
Mold spores are everywhere in our environment. They are in the air we breathe and on everything we touch. Most mold spores are harmless and usually killed by sunlight and some molds help with decomposition which helps plants reuse nutrients and recycle our air. Spores themselves don’t usually cause any problems, but when they are exposed to a constant source of moisture, the resulting growth of mold colonies presents a real hazard to building structures.
Once passive mold spores turn into active colonies, they can decompose permanent structures such as wood and drywall and they can become toxic to those living in the home. When mold colonies are discovered, it is important to have the mold removed while treating the structure with proper remediation techniques to prevent any further mold growth and damage. Apple Environmental uses high quality treatments that are non-hazardous to human health to get rid of your mold and prevent it from growing again.
Although there are over 100,000 known species of mold, some common household and commercial structure molds found during testing are: Aspergillus Penicillium, Cladosporium (green/black in color and powdery) and Stachybotrys (slimy-feeling and black, it is often called Toxic Black mold). The health problems caused by these molds vary depending on type, but the threat is very real: especially for the very young, the elderly, and those prone to respiratory problems. Unfortunately, some types of mold can even lead to a depressed immune system or cause certain kinds of cancer.
Physical Symptoms of Mold Contamination to Watch For:
- Skin rash and itching
- Eye irritation
- Congestion
- Asthma or aggravation of existing asthma
- Lung infection
- Flu-like symptoms that don’t go away
- Fatigue
- Respiratory dysfunction
- Frequent and excessive nose bleeds
- Dizziness
- Headaches
- Vomiting and more
Effects may range from the very mild to very severe, and some mold-related illnesses even require hospitalization. One way to determine whether or not your symptoms are related to your home or not is to go on vacation and pay attention to whether or not the symptoms go away.

Mold testing is an important precaution to protect your home and the health of your family. Every home contains mold and the potential for mold to grow and cause structural damage as well as health hazards for your family. Keeping moisture accumulating areas well ventilated and keeping an eye out for physical symptoms of mold growth are important parts of preventing serious damage caused by mold.
Apple Environmental’s mold testing professionals are available to test your home or building for mold as soon as you suspect a mold problem. Early detection can prevent costly repairs and can prevent the mold growth from spreading and causing serious health problem. Although most adults have an immune system capable of fighting toxic mold, young children and the elderly are at high risk of serious health problems and even death if mold symptoms are left unnoticed.
Apple Environmental mold testing technology and procedures include:
- Infrared (FLIR) Technology
- Protimeter Measurements
- ATP Swabs
- Air Sampling
- Surface Swabs

Mold can be hard to see, especially if it is growing behind walls or under roofing shingles so your nose and any physical symptoms are your best allies. Mold has a distinctive musty odor that is easy to recognize. There are also several physical symptoms including rash, eye irritation, headaches and asthma that may indicate a mold problem. If you are experiencing any mold symptoms it is important to have your home tested for mold.
If you are experiencing symptoms or notice any mold smells you may also wanted to have your home tested if you have had problems with leaky pipes, a leaky roof or accumulating moisture. A crawl space or attic in your home may be harboring mold that you are unaware of.

Nearly every Utah home will experience mold growth at some point. If proper mold cleanup and decontamination efforts are made, the mold growth can be stopped and your home will be safe. Apple Environmental uses advanced technology and products to find, test and completely decontaminate any mold contaminated area of your home.
The mold cleanup products stop mold growth and can prevent any future mold growth with a human and pet safe formula. Apple Environmental uses the best available mold cleanup and decontamination products to offer our customers safe and effective solution to mold problems. We kill mold to keep your family safe.

When buying a house it is important to have a mold inspection prior to closing the deal. If there is existing mold in the home, you can adjust your offer and negotiations accordingly. Apple Environmental helps homebuyers of a mold contaminated property by performing a thorough mold inspection and properly killing and decontaminating all molds in the home.
If mold is found during the inspection of the home a mold test should be performed immediately by a professional mold testing company. Apple Environmental performs mold tests to determine the type of mold, health dangers and the extent of decontamination needed to make the home a safe place to live. Don’t purchase a home without knowing what extent of mold remediation is needed.
It is especially important to know about any mold issues when buying a rental property. In addition to mold removal expenses, you may also be responsible for additional expenses such as tenant displacement during the mold removal process. For complete Utah landlord responsibilities regarding mold issues in a rental property see the Utah renters handbook.

Many brokers and REO agents face problems with selling a mold contaminated property. The buyers may be hesitant to purchase the home with existing mold. When selling a mold contaminated property it is important to have a mold inspection done in order to be aware of existing mold conditions and what processes are needed for mold remediation.
Apple Environmental helps brokers and REO agents in Utah with mold problems. We thoroughly clean and decontaminate properties with mold growth to get the home ready to sell. With the use of SafeHouse First mold cleanup products, Apple Environmental provides effective mold removal services that are safe for humans and pets. Don’t let mold keep you from selling a home.

